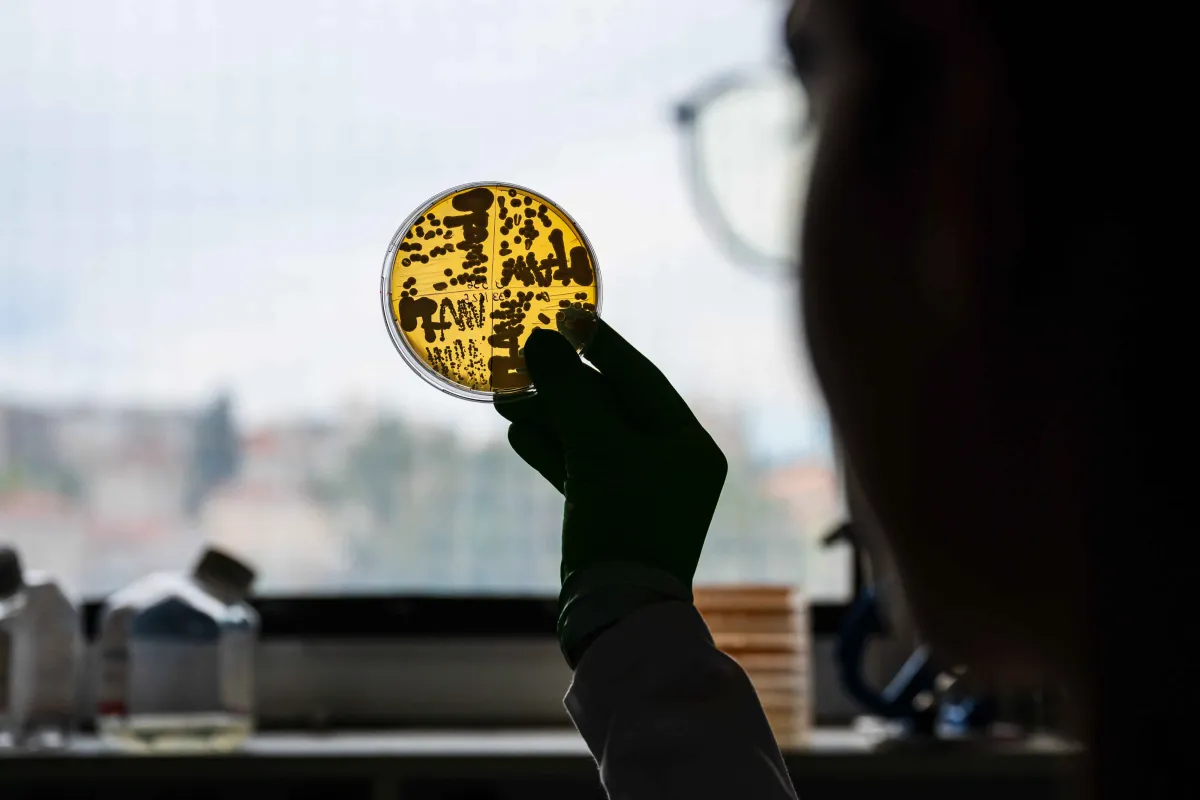

Gianni Liti La grande évolution des levures du genre Saccharomyces
Gianni Liti, directeur de recherche CNRS, chef de l'équipe « Génomique des populations et analyse des caractères complexes » à l'Institut de recherche sur le cancer et le vieillissement de Nice (IRCAN)
- 2024 • Impulscience

Les micro-organismes évoluent dans des communautés complexes. Ces dernières sont connectées entre elles par un réseau dense d’interactions à la base de tous les écosystèmes de la planète. Gianni Liti a pour intention de produire une vue d’ensemble de ces interactions. Pour cela, il a choisi un micro-organisme bien particulier : Saccharomyces cerevisiae. Plus connu sous le nom de levure de boulanger, il s’agit aussi d’un organisme modèle précieux pour les scientifiques.
Dévoiler l’architecture génétique des Saccharomyces
Les interactions entre les différentes espèces de micro-organismes ont très probablement un impact sur leurs histoires évolutives. À ce jour, les mécanismes sous-jacents qui génèrent ces phénomènes biologiques ne sont pas connus. Ce qui est certain, c’est que les communautés microbiennes de Saccharomyces varient en fonction de la géographie et de l'écologie, c’est-à-dire des milieux dans lesquels elles vivent, et de leurs rapports avec ces milieux.
Les recherches menées par Gianni Liti et son équipe ont contribué au développement de la levure Saccharomyces en tant que modèle pour les biologistes, et plus particulièrement pour l'étude de la génomique des populations. Le chercheur a récemment entrepris d’analyser 1 011 génomes de Saccharomyces cerevisiae, ce qui correspond à une grande partie de la variation génétique naturelle de cette espèce sur Terre. Grâce à cela, il dispose désormais de l’une des meilleures compréhensions de la diversité chez un organisme modèle eucaryote. Ce travail est crucial pour l’étude des autres eucaryotes, comme l’humain, les animaux et les végétaux, qui se caractérisent tous par la présence d’un noyau renfermant l’ADN au cœur de leurs cellules.
Décrypter les variations au sein des génomes
En entreprenant des études génomiques, qui s’intéressent à l’ensemble des gènes et des chromosomes chez un organisme, Gianni Liti a mis en évidence l’origine asiatique de la levure Saccharomyces. Il a également pointé les différences génétiques existant entre les espèces domestiques et les espèces sauvages. Ses travaux ont, entre autres, révélé l’impact des activités humaines sur la structure des populations de Saccharomyces.
En utilisant des approches génétiques de pointe, il cherche aujourd’hui à comprendre comment les levures Saccharomyces interagissent avec les communautés microbiennes qui coexistent avec elles dans un environnement donné.
Comprendre les relations entre les micro-organismes à tous les niveaux
Gianni Liti et son équipe envisagent de fournir une vue d’ensemble des interactions microbiennes de la levure Saccharomyces. Leur idée est de mesurer l’incidence de ces interactions sur les gènes, leur expression et le cycle de vie des individus.
Impulscience® leur permettra d'élucider les communautés microbiennes de Saccharomyces à travers des centaines de niches écologiques, sauvages et domestiques. Dans un second temps, ils analyseront, en laboratoire, les interactions entre les cellules Saccharomyces et les autres espèces des communautés microbiennes. Ils évalueront également l'impact de ces interactions sur le transfert de certains gènes entre espèces ou entre cellules de levure infectées par des bactéries. Le but ultime de ce projet est donc de révéler les bases moléculaires des interactions entre espèces et d'en déduire le rôle qu'elles ont joué dans l'évolution des espèces de Saccharomyces.
Gianni Liti en quelques mots
Gianni Liti a soutenu sa thèse de doctorat en 2000, à l’Université de Pérouse, en Italie. Après une dizaine d’années passées au Royaume-Uni en post-doctorat, il crée son équipe de recherche à l'Institut de recherche sur le cancer et le vieillissement de Nice (IRCAN) en 2012. Son équipe, "Génomique des Populations et Analyse des Caractères Complexes" est pionnière dans le développement de la levure Saccharomyces cerevisiae en tant que modèle puissant pour les études de génomique des populations et de génétique quantitative.

-
2000 Thèse de doctorat, Université de Pérouse, Italie
-
2012 Création de son équipe de recherche à l'Institut de recherche sur le cancer et le vieillissement de Nice (IRCAN)
-
2024 Impulscience®
Programme Impulscience
Impulscience attribue chaque année 7 nouveaux soutiens à des chercheuses et chercheurs en sciences de la vie. Concentré sur le milieu de carrière, ce programme a pour objectif de soutenir cette étape cruciale pour le développement des projets de recherche.
Tous les lauréats du prixAppel à candidatures
L'appel à candidatures est ouvert du 7 avril 2026 au 21 mai 2026 pour les candidats ayant répondu aux appels à projet ERC Starting et Consolidator 2025 ; et jusqu'au 22 juin 2026 pour les candidats ayant répondu à l'appel à projet ERC Advanced 2025.